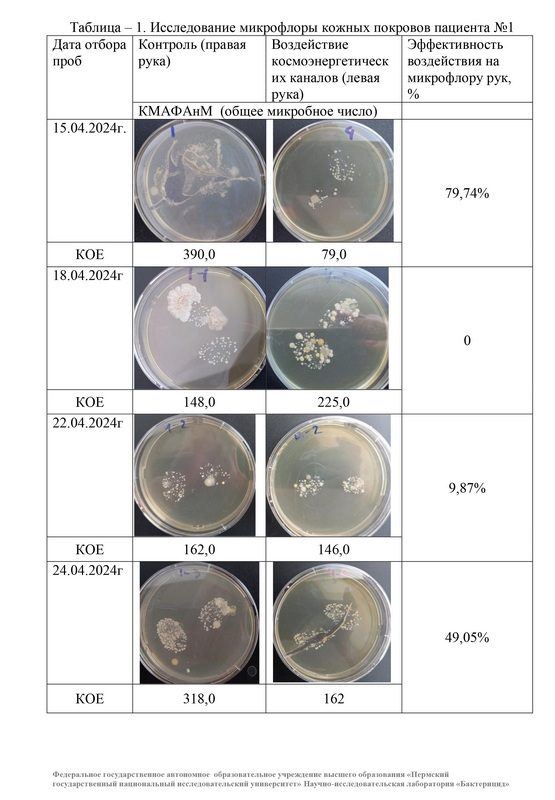
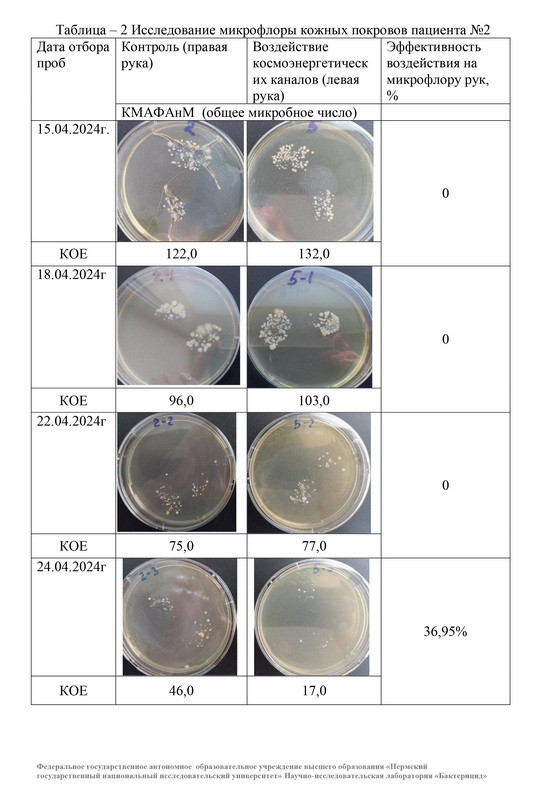
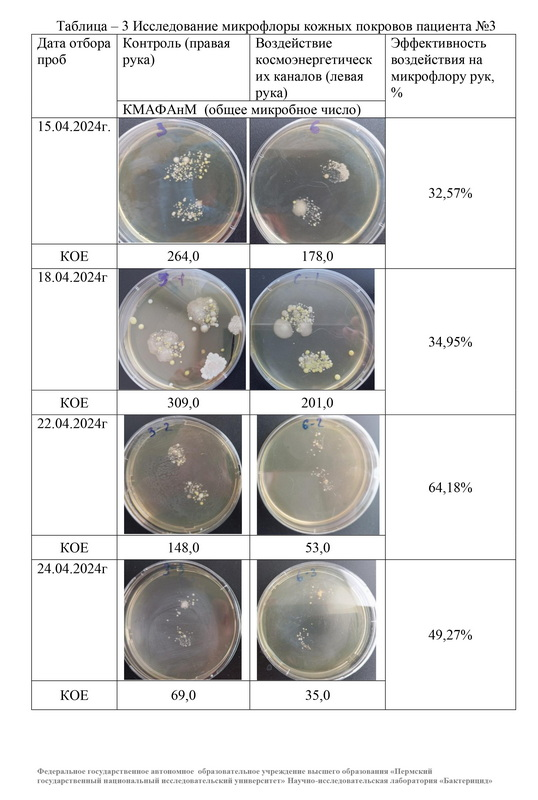

Руки Человека, одни из основных наших конечностей, которые значительно облегчают нашу жизнь и тем не менее являются одним из основных носителей и переносчиков различных, невидимых глазу человека микроорганизмов и бактерий. Мойте руки перед едой! Эту фразу, мы слышим с раннего детства и лишь в осознанном возрасте понимаем для чего это необходимо делать. Безусловно, есть и те, кто понимая - продолжает пренебрегать, а что, один раз живем, думают и говорят они, хотя конечно, это далеко от истины (жизней будет много), а вот память о них, закроют.
А что делать, если вы проехались, например в метро, и очень хотите скушать вкуснейшую на свете булочку, а воды и мыла рядом нет? Голод, как говориться не тетка, а иммунитет не железный. Расстройство пищеварения спишется на некачественный продукт и ни коим образом на свою ответственность за миллиарды проглоченных бактерий. У космоэнергетов на такой случай есть метод классическая космоэнергетика, а всем остальным, рекомендую, потерпеть до дома и вымыть таки свои руки с мылом!
В разделе видео, есть разбор данного исследования, и так:
Оператором и участником проведенного исследования, являлась Татьяна Самутина, Магистр классической космоэнергетики.
Школа, ученики и специалисты по работе методом классическая космоэнергетика, коренным образом отличаются от специалистов, операторов и Магистров других школ космоэнергетики, не являющейся классической. Мы Используем в своей работе знания без изменений, искажений и нововведений, так, как это делали до нас на протяжении прошлых времен. Будьте осмотрительны при посещении сеансов и выборе специалиста. Сеансы не могут длиться менее 40 минут и проводятся как правило в положении "расслабленная стойка", т.е. стоя. Исключением может являться только тяжелое состояние Человека, который физически не может стоять. Допускается проведение сеансов на расстоянии, при этом расстояние значения не имеет, а вот знания и посвящения, проводятся только очно, при вашем личном присутствии и дистанта здесь, уже нет!
ФЕДЕРАЛЬНОЕ ГОСУДАРСТВЕННОЕ АВТОНОМНОЕ ОБРАЗОВАТЕЛЬНОЕ УЧРЕЖДЕНИЕ ВЫСШЕГО ОБРАЗОВАНИЯ ПЕРМСКИЙ ГОСУДАРСТВЕННЫЙ НАЦИОНАЛЬНЫЙ ИССЛЕДОВАТЕЛЬСКИЙ УНИВЕРСИТЕТ 614990, г. Пермь, ГСП, ул. Букирева, 15.
УТВЕРЖДАЮ
Зав. научно-исследовательской
лаборатории «Бактерицид»
С.Ю. Баландина
ТЕМА: ИССЛЕДОВАНИЕ МИКРОБНОЙ ОБСЕМЕНЕННОСТИ КОЖИ РУК ЧЕЛОВЕКА ПРИ РАБОТЕ КОСМОЭНЕРГЕТИЧЕСКИМИ КАНАЛАМИ
Дата: 26.04.2024г.
Место проведения опыта: научно-исследовательская лаборатория «Бактерицид» Пермского государственного национального исследовательского университета, лицензия №59.55.11.001.Л.000031.05.08 от 08.05.2008 г. Управление Федеральной службы по надзору в сфере защиты прав потребителей и благополучия человека по Пермскому краю.
Температура в помещении: 22 - 24 °С
Федеральное государственное автономное образовательное учреждение высшего образования «Пермский
государственный национальный исследовательский университет» Научно-исследовательская лаборатория «Бактерицид»
Заключение по результатам исследования микробной обсемененности
кожи рук человека при работе космоэнергетическими каналами
В научно-исследовательской лаборатории «Бактерицид» ПГНИУ проведены исследования микробной обсемененности кожных покровов рук.
Объектом исследования явилась микрофлора кожных покровов рук пациентов до и после сеанса воздействия космоэнергетическими каналами. Бактериологическое исследование микробной контаминации предусматривало исследование на выявление параметров общей обсемененности микроорганизмами (сапрофитная микрофлора)..
Метод исследований:
Исследование кожных покровов проводили методом «отпечатков» указательного и большого пальцев, с использованием питательного рыбопептонного агара (РПА). В качестве контроля служили полученные результаты выросших микроорганизмов, отобранных методом «отпечатка» с правой руки пациента, экспериментальные результаты (после сеанса) оценивали после воздействия сеанса с левой руки. Длительность сеанса составляла 40мин.
Для определения общего количества мезофильных аэробных и факультативно-анаэробных бактерий (кмафанм) чашки Петри с «отпечатками» пальцев помещали в термостат при ^С = 37±1°С, на 48 ± 3 часа.
Для изучения воздействия космоэнергетических каналов были приглашены пациенты, добровольцы (женщины):
- пациент №1
- пациент №2
- пациент №3
Результаты исследований:
Изучение микрофлоры пальцев рук проводилось в одно и тоже время в течение 4-х сеаносов. Пациенты прикладывали указательный и большой палец к плотной питательной среде РПА на чашки Петри сначало правой руки (контроль), через 40мин., после сеанса воздействия космоэнергетических каналов прикладывали пальцы левой руки на плотную питательную среду РПА.
Далее чашки Петри с «отпечатками» помещались в термостат, где инкубировались в течение 48± 3 ч. при температуре КС = 37±1°С. После чего подсчитывалось общее количество выросших колониеобразующих единиц (КОЕ) микроорганизмов. Полученные результаты представлены в таблицах 1-3.
Из данных таблицы следует, что восприятие организма пациентов сеанса воздействия космоэнергетических каналов различно. Исходя из полученных данных таблиц 1-3 следует, что у пациента №1 восприятие сеансов происходит пикообразно, эффективность воздействия изначально увеличивается, затем отсутствует, далее снова увеличивается и.т.д.; у пациента №2 только на 4-ый сеанс, количество микроорганизмов снизилось, по сравнению с контролем (правая рука), характерно то, что с каждым сеансом количество микроорганизмов на обеих руках систематически снижалось; на пациента №3 происходило стабильное воздействие, количество микроорганизмов регулярно снижалось на кожных покровах рук, по сравнению с контролем, кроме того обсемененность кожных покровов рук на 3-й сеанс стала снижаться обеих рук.
А что делать, если вы проехались, например в метро, и очень хотите скушать вкуснейшую на свете булочку, а воды и мыла рядом нет? Голод, как говориться не тетка, а иммунитет не железный. Расстройство пищеварения спишется на некачественный продукт и ни коим образом на свою ответственность за миллиарды проглоченных бактерий. У космоэнергетов на такой случай есть метод классическая космоэнергетика, а всем остальным, рекомендую, потерпеть до дома и вымыть таки свои руки с мылом!
В разделе видео, есть разбор данного исследования, и так:
Оператором и участником проведенного исследования, являлась Татьяна Самутина, Магистр классической космоэнергетики.
Школа, ученики и специалисты по работе методом классическая космоэнергетика, коренным образом отличаются от специалистов, операторов и Магистров других школ космоэнергетики, не являющейся классической. Мы Используем в своей работе знания без изменений, искажений и нововведений, так, как это делали до нас на протяжении прошлых времен. Будьте осмотрительны при посещении сеансов и выборе специалиста. Сеансы не могут длиться менее 40 минут и проводятся как правило в положении "расслабленная стойка", т.е. стоя. Исключением может являться только тяжелое состояние Человека, который физически не может стоять. Допускается проведение сеансов на расстоянии, при этом расстояние значения не имеет, а вот знания и посвящения, проводятся только очно, при вашем личном присутствии и дистанта здесь, уже нет!
ФЕДЕРАЛЬНОЕ ГОСУДАРСТВЕННОЕ АВТОНОМНОЕ ОБРАЗОВАТЕЛЬНОЕ УЧРЕЖДЕНИЕ ВЫСШЕГО ОБРАЗОВАНИЯ ПЕРМСКИЙ ГОСУДАРСТВЕННЫЙ НАЦИОНАЛЬНЫЙ ИССЛЕДОВАТЕЛЬСКИЙ УНИВЕРСИТЕТ 614990, г. Пермь, ГСП, ул. Букирева, 15.
УТВЕРЖДАЮ
Зав. научно-исследовательской
лаборатории «Бактерицид»
С.Ю. Баландина
ТЕМА: ИССЛЕДОВАНИЕ МИКРОБНОЙ ОБСЕМЕНЕННОСТИ КОЖИ РУК ЧЕЛОВЕКА ПРИ РАБОТЕ КОСМОЭНЕРГЕТИЧЕСКИМИ КАНАЛАМИ
Дата: 26.04.2024г.
Место проведения опыта: научно-исследовательская лаборатория «Бактерицид» Пермского государственного национального исследовательского университета, лицензия №59.55.11.001.Л.000031.05.08 от 08.05.2008 г. Управление Федеральной службы по надзору в сфере защиты прав потребителей и благополучия человека по Пермскому краю.
Температура в помещении: 22 - 24 °С
Федеральное государственное автономное образовательное учреждение высшего образования «Пермский
государственный национальный исследовательский университет» Научно-исследовательская лаборатория «Бактерицид»
Заключение по результатам исследования микробной обсемененности
кожи рук человека при работе космоэнергетическими каналами
В научно-исследовательской лаборатории «Бактерицид» ПГНИУ проведены исследования микробной обсемененности кожных покровов рук.
Объектом исследования явилась микрофлора кожных покровов рук пациентов до и после сеанса воздействия космоэнергетическими каналами. Бактериологическое исследование микробной контаминации предусматривало исследование на выявление параметров общей обсемененности микроорганизмами (сапрофитная микрофлора)..
Метод исследований:
Исследование кожных покровов проводили методом «отпечатков» указательного и большого пальцев, с использованием питательного рыбопептонного агара (РПА). В качестве контроля служили полученные результаты выросших микроорганизмов, отобранных методом «отпечатка» с правой руки пациента, экспериментальные результаты (после сеанса) оценивали после воздействия сеанса с левой руки. Длительность сеанса составляла 40мин.
Для определения общего количества мезофильных аэробных и факультативно-анаэробных бактерий (кмафанм) чашки Петри с «отпечатками» пальцев помещали в термостат при ^С = 37±1°С, на 48 ± 3 часа.
Для изучения воздействия космоэнергетических каналов были приглашены пациенты, добровольцы (женщины):
- пациент №1
- пациент №2
- пациент №3
Результаты исследований:
Изучение микрофлоры пальцев рук проводилось в одно и тоже время в течение 4-х сеаносов. Пациенты прикладывали указательный и большой палец к плотной питательной среде РПА на чашки Петри сначало правой руки (контроль), через 40мин., после сеанса воздействия космоэнергетических каналов прикладывали пальцы левой руки на плотную питательную среду РПА.
Далее чашки Петри с «отпечатками» помещались в термостат, где инкубировались в течение 48± 3 ч. при температуре КС = 37±1°С. После чего подсчитывалось общее количество выросших колониеобразующих единиц (КОЕ) микроорганизмов. Полученные результаты представлены в таблицах 1-3.
Из данных таблицы следует, что восприятие организма пациентов сеанса воздействия космоэнергетических каналов различно. Исходя из полученных данных таблиц 1-3 следует, что у пациента №1 восприятие сеансов происходит пикообразно, эффективность воздействия изначально увеличивается, затем отсутствует, далее снова увеличивается и.т.д.; у пациента №2 только на 4-ый сеанс, количество микроорганизмов снизилось, по сравнению с контролем (правая рука), характерно то, что с каждым сеансом количество микроорганизмов на обеих руках систематически снижалось; на пациента №3 происходило стабильное воздействие, количество микроорганизмов регулярно снижалось на кожных покровах рук, по сравнению с контролем, кроме того обсемененность кожных покровов рук на 3-й сеанс стала снижаться обеих рук.
Таблица - 1. Исследование микрофлоры кожных покровов пациента №1
Таблица - 2 Исследование микрофлоры кожных покровов пациента №2
Таблица - 3 Исследование микрофлоры кожных покровов пациента №3
Графики 1 2 3 4

Рис. 4 Эффективность воздействия на микрофлору рук, %

Выводы
1. Проведены исследования микробной обсемененности кожных покровов рук человека при работе космоэнергетическими каналами, в течение 4-х сеансов, длительностью в 40мин., с участием трех пациентов, добровольцев.
2. Установлено, что после воздействия сеансов, количество микроорганизмов на кожных покровах рук снижается, что хорошо показано, на примере пациента №3 (32,57 - 64,18% эффективность снижения по сравнению с контролем).
3. Определено, что воздействие космоэнергетическими каналами на организм более эффективно, при работе от 3-х и более сеансов.
Зав. НИЛ «Бактерицид»
С.Ю. Баландина
1. Проведены исследования микробной обсемененности кожных покровов рук человека при работе космоэнергетическими каналами, в течение 4-х сеансов, длительностью в 40мин., с участием трех пациентов, добровольцев.
2. Установлено, что после воздействия сеансов, количество микроорганизмов на кожных покровах рук снижается, что хорошо показано, на примере пациента №3 (32,57 - 64,18% эффективность снижения по сравнению с контролем).
3. Определено, что воздействие космоэнергетическими каналами на организм более эффективно, при работе от 3-х и более сеансов.
Зав. НИЛ «Бактерицид»
С.Ю. Баландина
Источник: https://www.chermanteev.ru/blog/nauka-i-meditsina/issledovaniya-vliyaniya-metoda-na-bakterii-i-mikroby.html